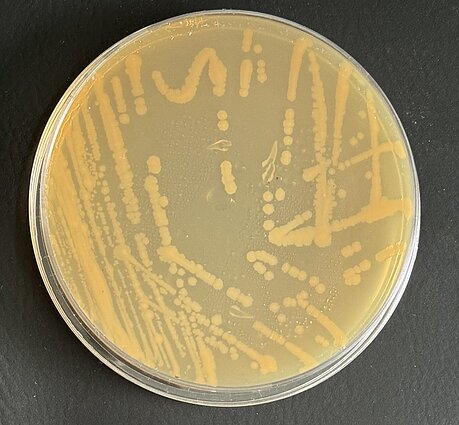

Mikroorganizmai ir jų vaidmuo švarinant planetą
Aukščiau aprašytuose gamybos procesuose svarbų vaidmenį vaidina mikroorganizmai. Augalinės kilmės medžiagos yra jautrios mikroorganizmų poveikiui, todėl jų gamybos ir eksploatavimo metu mikroorganizmų buvimas bei augimas nėra pageidautinas. Nuo jo turi būti apsisaugoma palaikant tinkamą temperatūrą ir drėgmę ir/ar padengiant medžiagų paviršių apsauginėmis dangomis, kurioms gali būti taip pat panaudojami bioskaidūs produktai, pvz. augalinės kilmės aliejai. Tačiau pereinant iš techninio į biologinį žiedinės ekonomikos ciklą, mikroorganizmų veikla tampa labai svarbi komposto bei biodujų gamyboje, nes abiejuose procesuose dalyvauja jų bendrijos, susidedančios daugiausia iš bakterijų, archėjų bei grybų. Dėl mikrobinio anaerobinio skaidymo susidaro biodujos, kurių pagrindinė pageidaujama sudedamoji dalis yra metanas. Tuo tarpu kompostavimo metu susidaro įvairaus suskaidymo lygio organinių medžiagų mišinys, turintis azoto, kalio ir fosforo junginių (NPK) bei mikroelementų. Tinkamai paruoštas kompostas neturi savyje patogenų bei nestabdo, o netgi skatina sėklų dygimą ir augimą.
Pastaraisiais metais yra plačiai tyrinėjimas plastiko skaidymas bei jam yrant susidarančio mikro-nanoplastiko poveikis aplinkai bei žmogui. Šių dalelių sukeliama žala yra viena iš priežasčių kodėl yra ieškomi mikroorganizmai bei jų fermentai, gebantys suskaidyti plastiko polimerus iki monomerų ar kitų lengvai skaidomų junginių. Mikrobiologijos bei genų inžinerijos dėka pasiekta tam tikros pažangos konstruojant efektyvius polietilentereftaliatą (PET, pakuotėse dažnai sutinkamą plastiką) skaidančius fermentus. Šie fermentai išskirti iš įvairių bakterijų bei grybų. Buvo parodyta, kad bakterijos Ideonella sakaiensis gali suskaidyti nedidelį (apie 60 mg) PET gabalėlį per 42 dienas. Tuo tarpu genų inžinerijos metodu patobulintas fermentas – lapų ir šakelių komposto kutinazė sugebėjo suskaidyti 1.3 g neapdorotų atliekų per mažiau nei 3 dienas. Taip pat ieškomi ir apibūdinantys fermentai, galintys skaidyti kitus plastikus. Vyrauja įsitikinimas, kad tradicinio plastiko pakeitimas bioplastiku sumažins taršą, nes patekęs į aplinką jis bus lengvai suskaidomas mikroorganizmais. Nors tai iš dalies išsprendžia užterštumo problemą, nes skaidymas gerai vyksta kontroliuojamomis sąlygomis, nekontroliuojamoje aplinkoje šis skaidymas gali nevykti taip sėkmingai. Yra žinoma, kad bioplastikas, kaip ir tradicinis plastikas, gali sudaryti sunkiai suskaidomas, toksiškas mikro- bei nanodaleles. Be to, šiuo metu dažnai (pvz. vienkartiniuose kavos puodeliuose) yra naudojami kompozitai. T. y. bioskaidus popierius/kartonas kartu su plastiku ar aliuminiu. Užrašams ant jų naudojami dažai. Siekiant kuo efektyviau skaidyti (bio)plastiką reikia tyrimų, kurie padės parinkti tinkamas sąlygas. Neabejotina, kad mikroorganizmai čia vaidins svarbų vaidmenį ir prisidės prie žiedinės ekonomikos vystymosi.
Plačiau apie darbščiuosius mikrobus ir žiedinę bioekonomiką sužinosite prof. dr. Jauniaus Urbonavičiaus paskaitoje „Mikroorganizmų svarba žiedinei ekonomikai“, kuri įvyks rugsėjo 13 d. 10 val. VGTU Chemijos ir bioinžinerijos katedroje, SRK-I 109 aud. (Saulėtekio al. 11, Vilnius). Būtina išankstinė registracija https://www.mokslofestivalis.eu/renginiai/
Komentarai